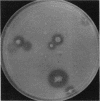
991

Abstract
A two-layer plate consisting of a lower indicator layer of milk-agar and an upper nutrient agar layer was developed for isolating proteolytic marine bacteria.
Full text
PDF

Images in this article
Selected References
These references are in PubMed. This may not be the complete list of references from this article.
- Kazanas N. Proteolytic activity of microorganisms isolated from freshwater fish. Appl Microbiol. 1968 Jan;16(1):128–132. doi: 10.1128/am.16.1.128-132.1968. [DOI] [PMC free article] [PubMed] [Google Scholar]
- Levin R. E. Detection and incidence of specific species of spoilage bacteria on fish. I. Methodology. Appl Microbiol. 1968 Nov;16(11):1734–1737. doi: 10.1128/am.16.11.1734-1737.1968. [DOI] [PMC free article] [PubMed] [Google Scholar]
- MERKEL J. R. METHOD FOR DETECTING AND ISOLATING PROTEOLYTIC MARINE BACTERIA. J Bacteriol. 1965 Mar;89:903–904. doi: 10.1128/jb.89.3.903-904.1965. [DOI] [PMC free article] [PubMed] [Google Scholar]